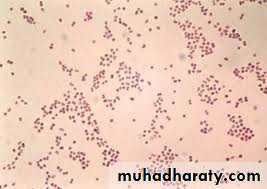
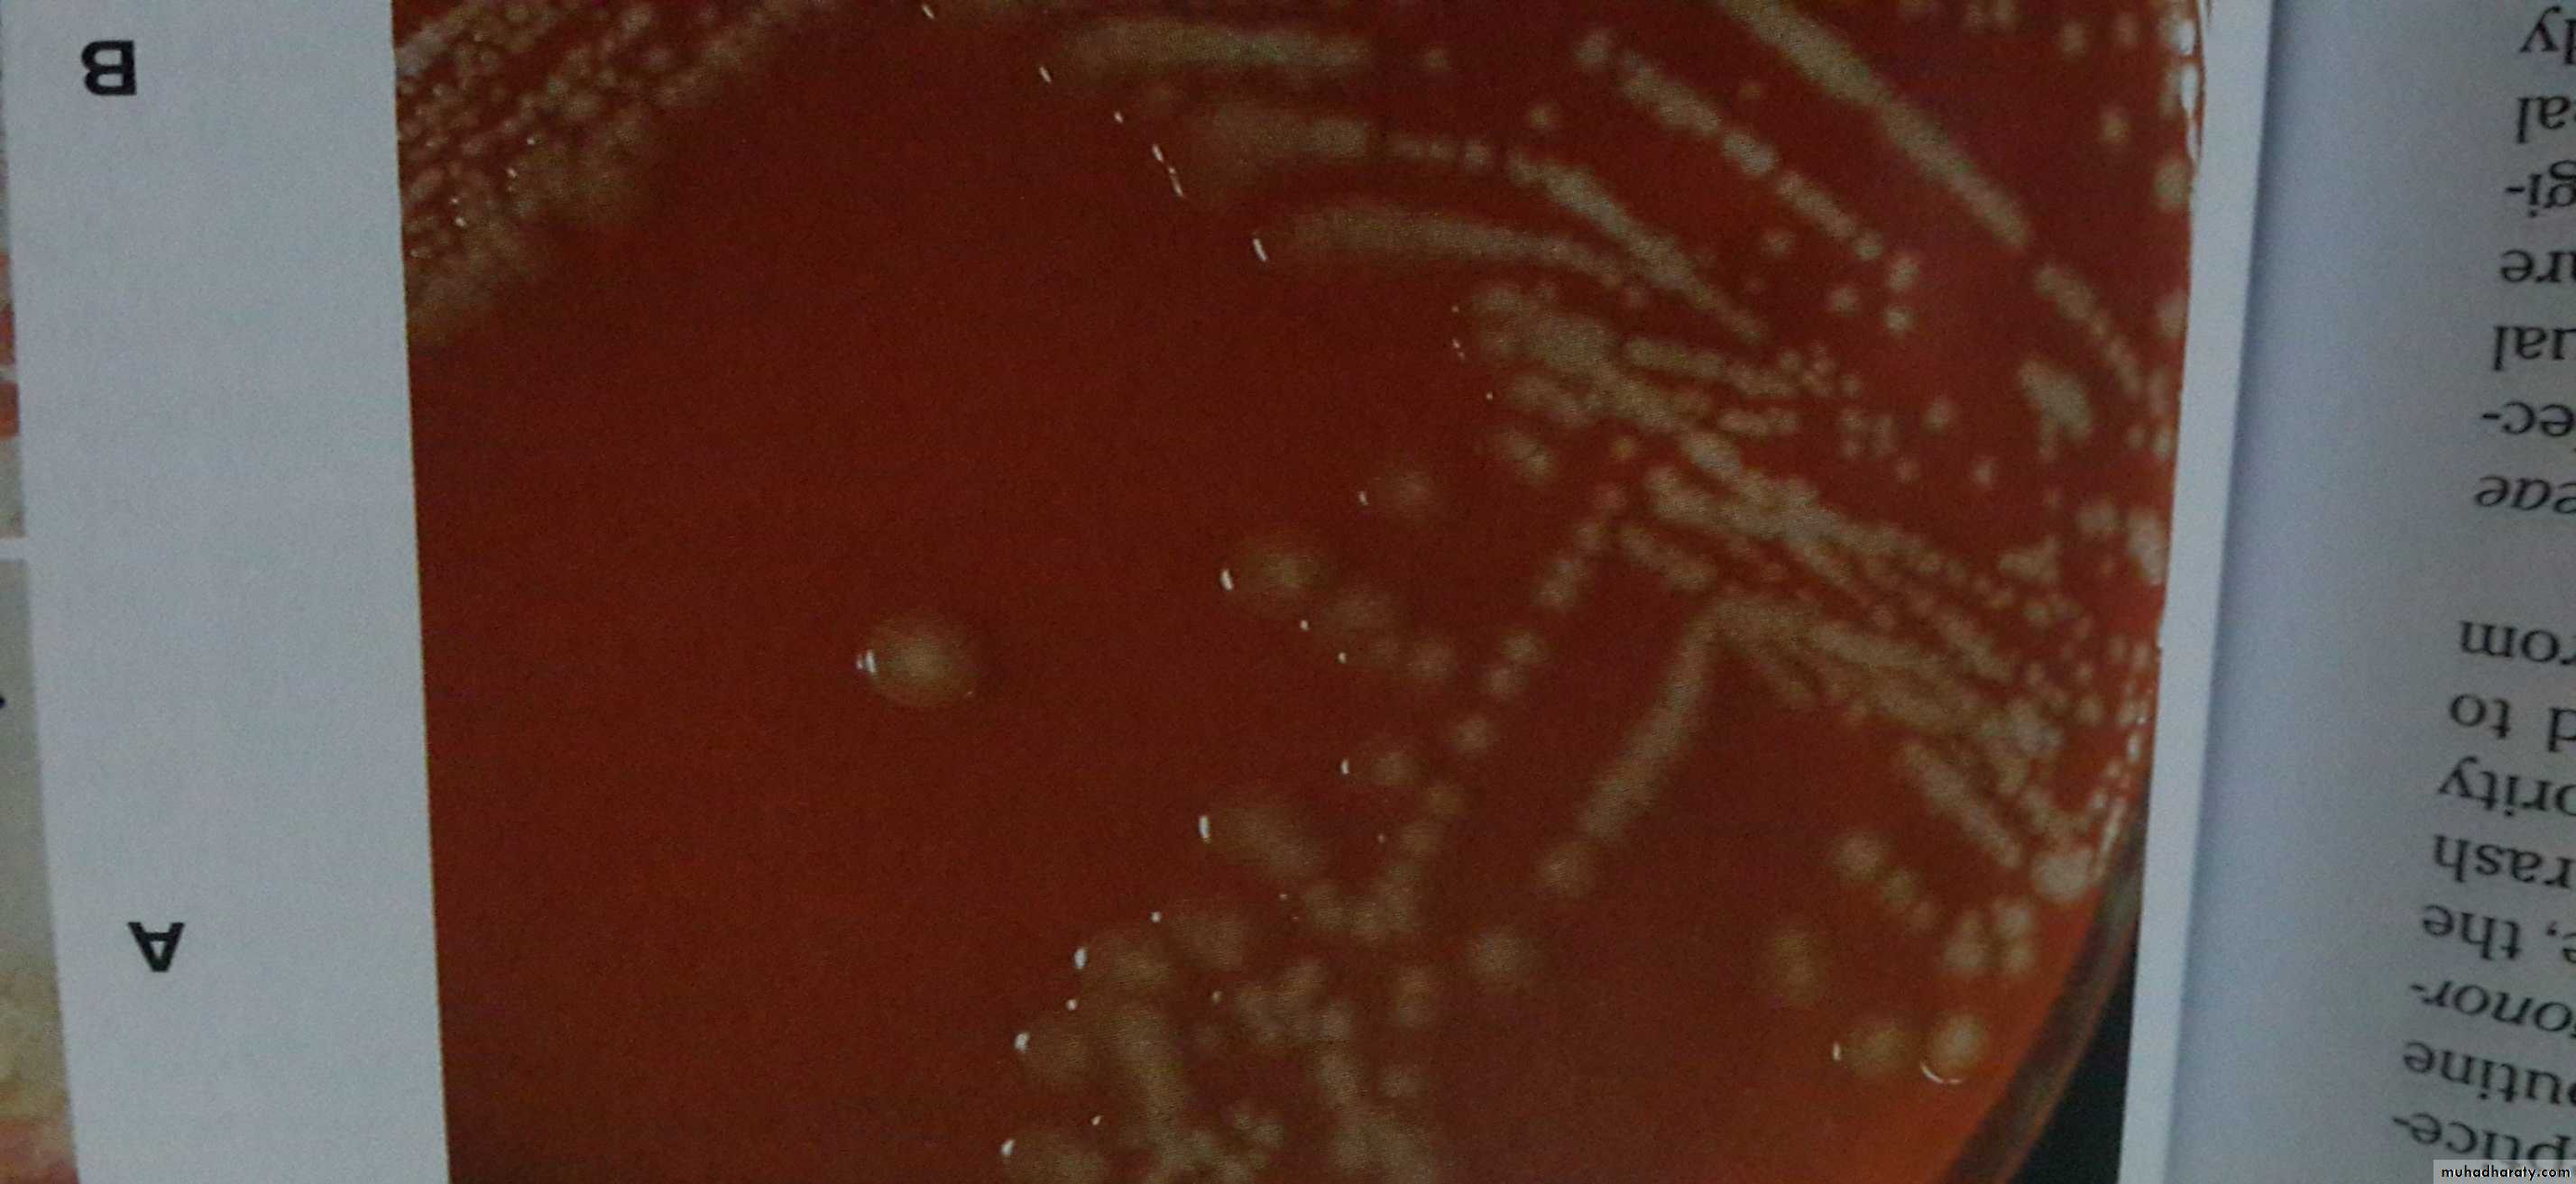
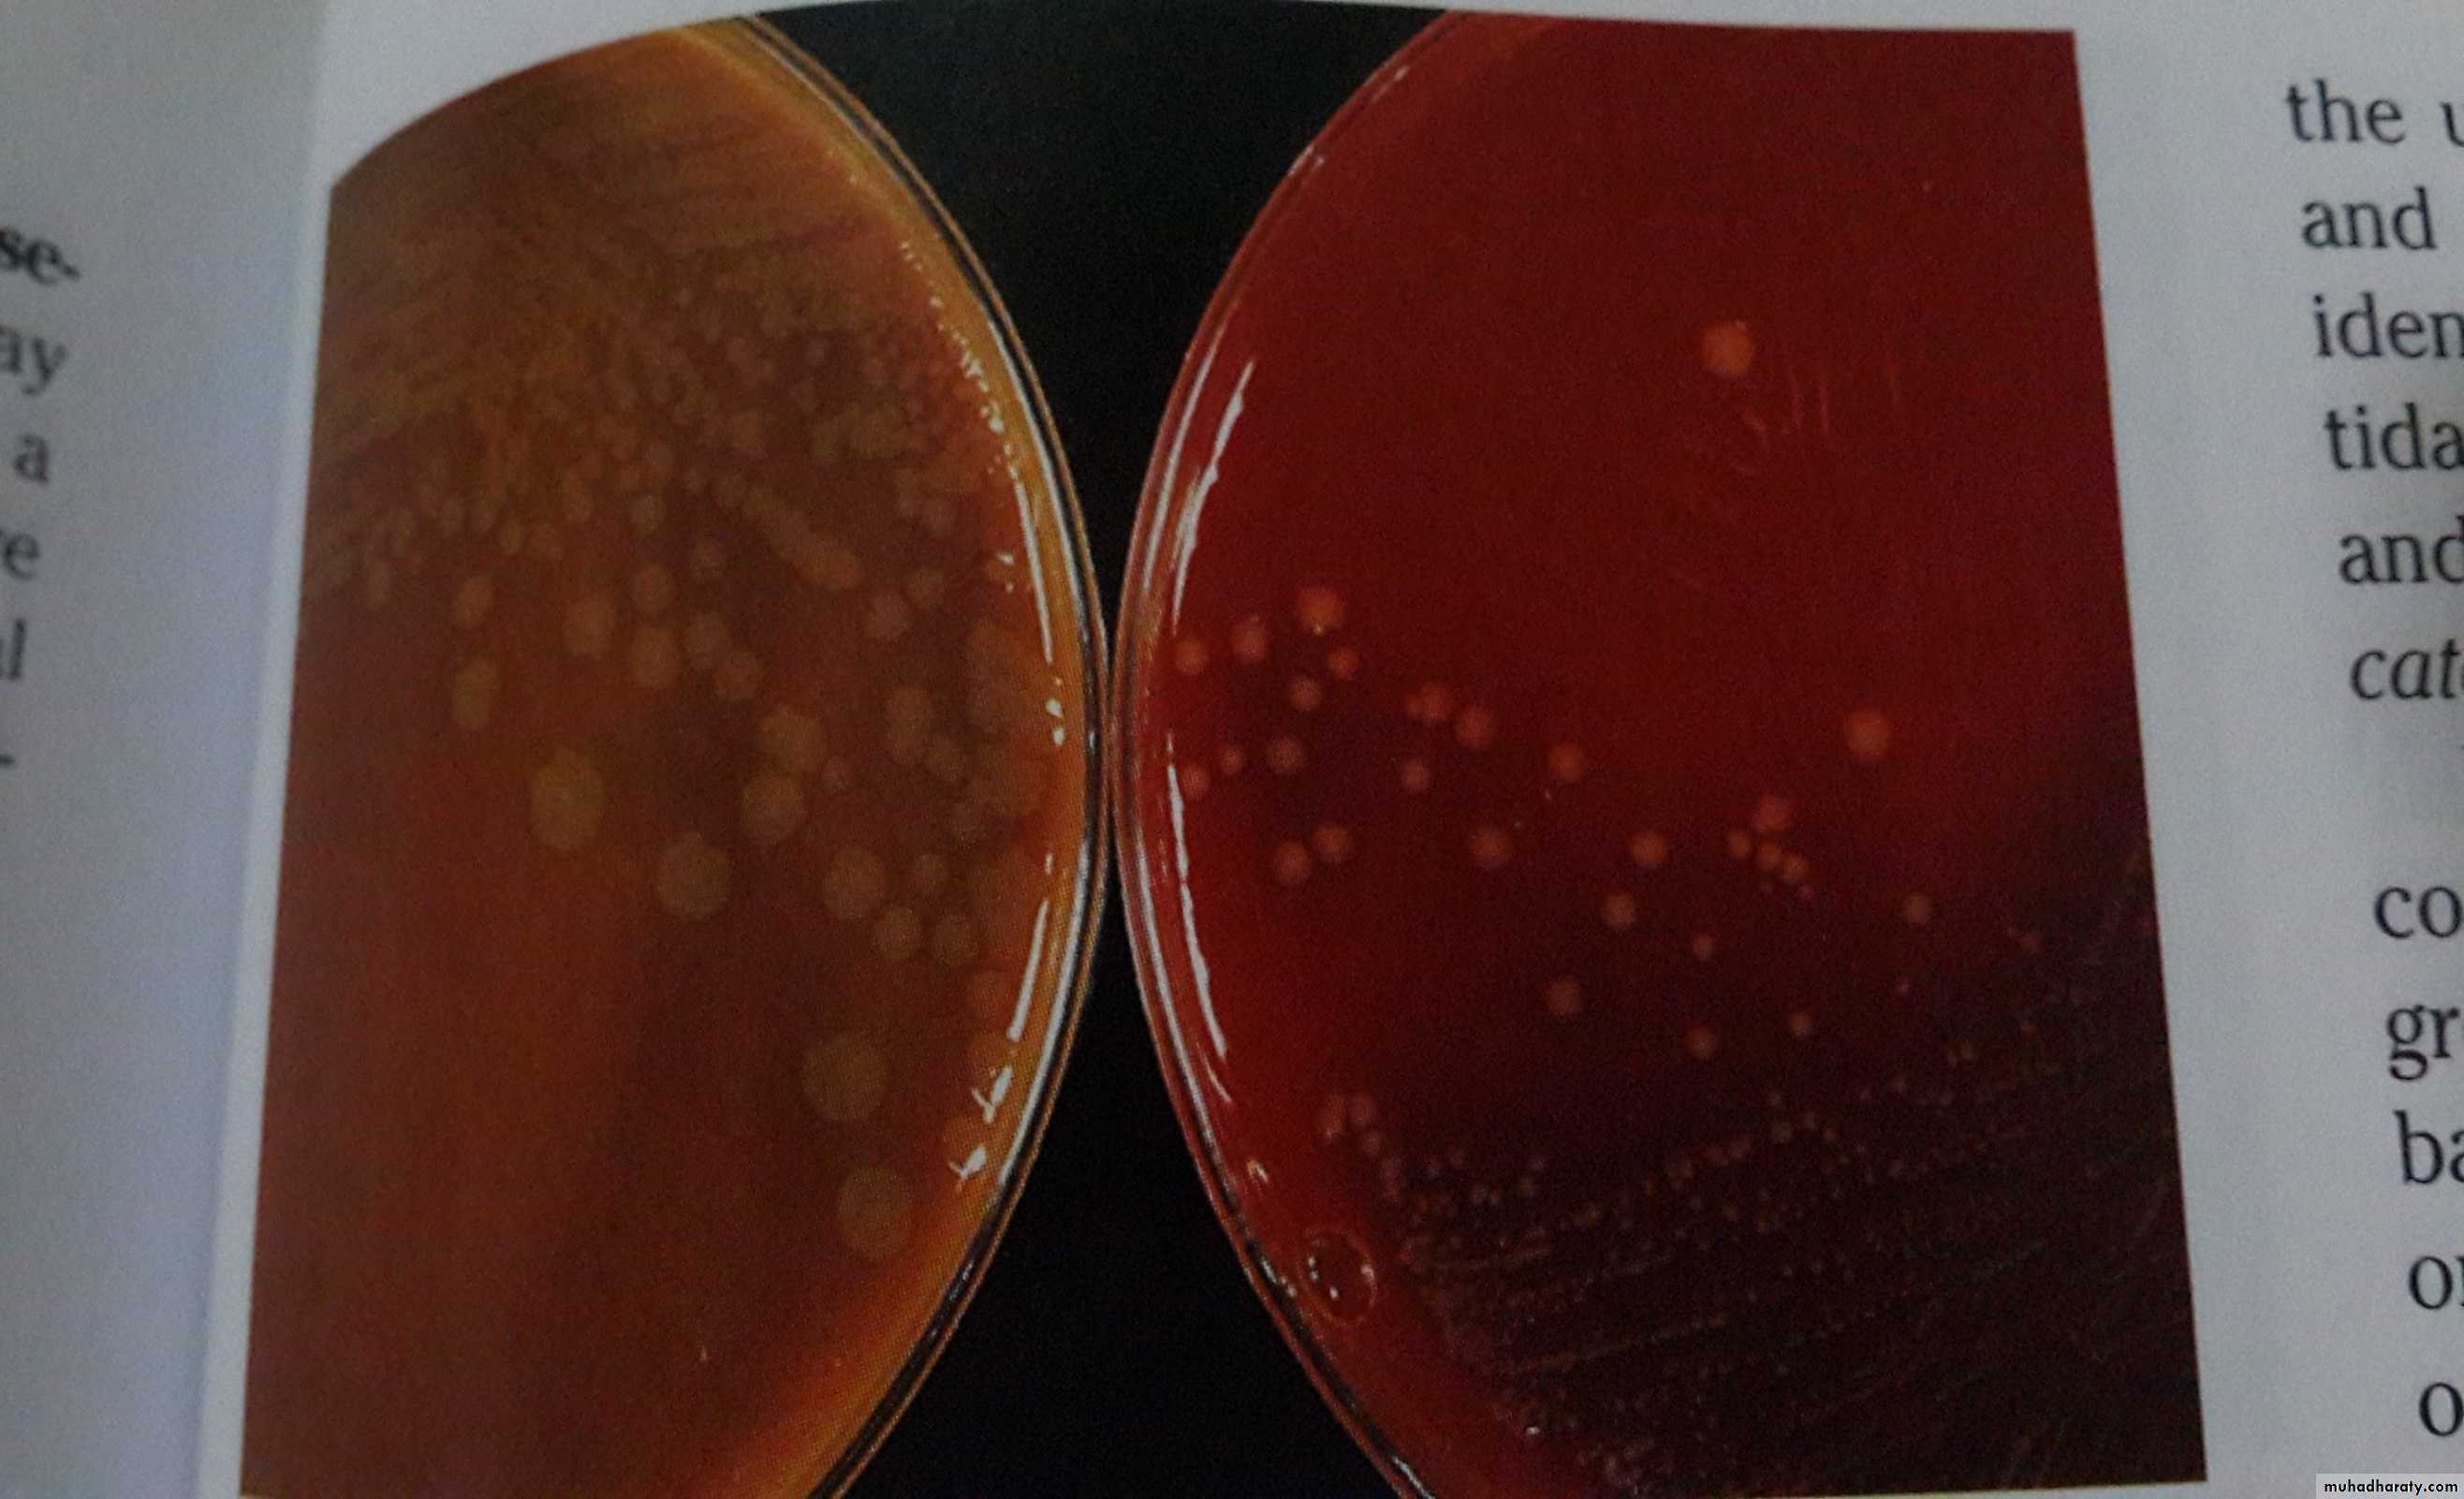
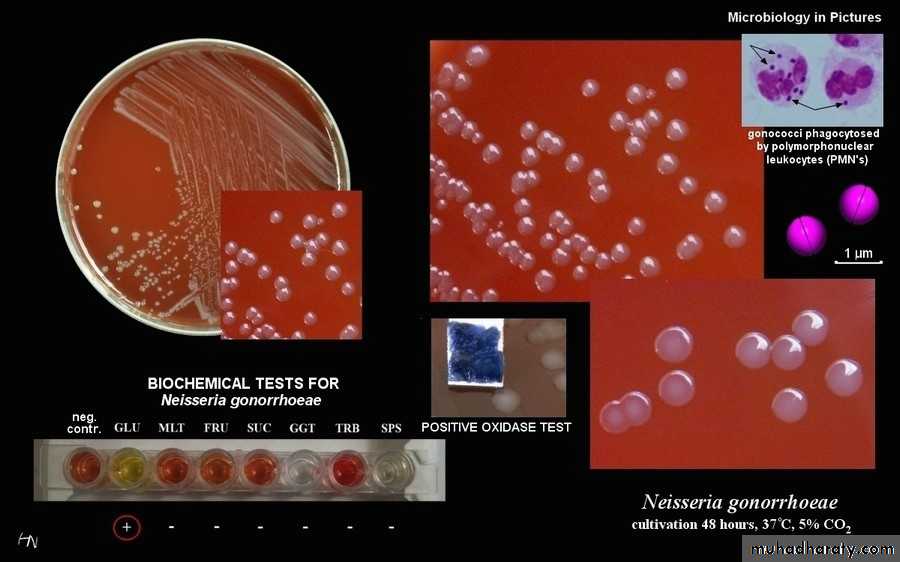
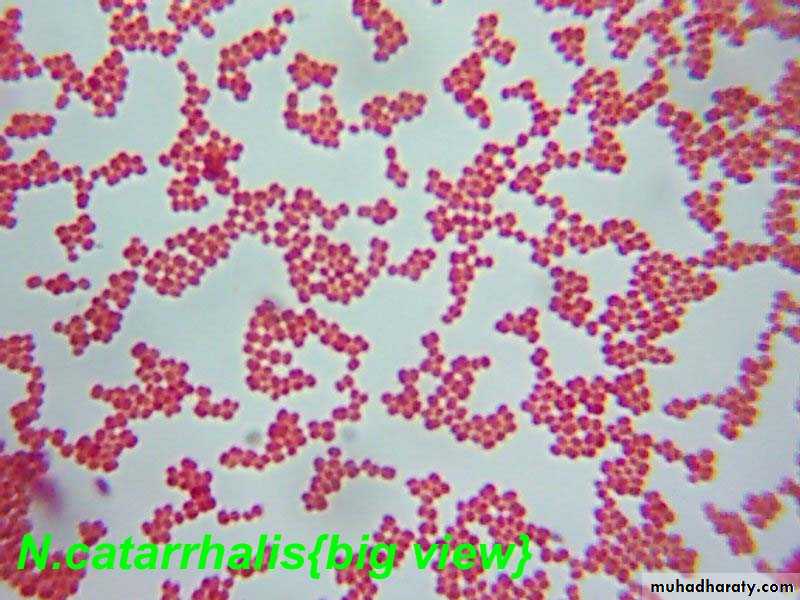
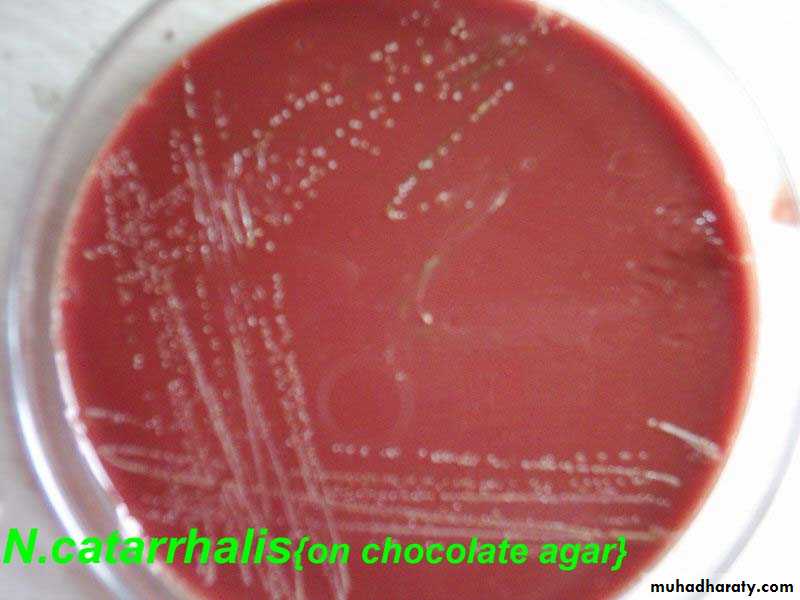

Family Neisseriaceae
Gram negative cocciThe Neisseriae
The family Neisseriaceae includes the genera Neisseria, Kingella …etc.The Neisseriae are gram-negative cocci that usually occur in pairs.
Neisseria gonorrhoeae (gonococci) and Neisseria meningitidis (meningococci) are pathogenic for humans and typically are found inside polymorphonuclear cells.
Some Neisseriae are normal inhabitants of the human respiratory tract, rarely if ever cause disease, and occur extracellularly.
Gonococci and meningococci are closely related, with 70% DNA homology, and are differentiated by a few laboratory tests and specific characteristics.
Meningeococci
Gonococcihave polysaccharide capsules
do not
rarely have plasmids
most gonococci do
found in the upper respiratory tract and cause meningitis
gonococci cause genital infections
Oxidizes glucose and maltose
Oxidizes glucose only
Morphology & Identification
Typical Organisms
The typical Neisseria is a gram-negative, nonmotile diplococcus, approximately 0.8 µm in diameter. Individual cocci are kidney-shaped; when the organisms occur in pairs, the flat or concave sides are adjacent.
Culture
In 48 hours on enriched media (eg, modified-Thayer Martin, Martin-Lewis, GC-Lect, and New York City), gonococci and meningococci form convex, glistening, elevated, mucoid colonies 1–5 mm in diameter. Colonies are transparent or opaque, nonpigmented, and nonhemolytic.
Growth Characteristics
The neisseriae grow best under aerobic conditions, but some will grow in an anaerobic environment.Most neisseriae oxidize carbohydrates, producing acid, and their carbohydrate patterns are a means of distinguishing them.
The neisseriae produce oxidase and give positive oxidase reactions. When bacteria are spotted on a filter paper soaked with tetramethylparaphenylenediamine hydrochloride (oxidase), the neisseriae rapidly turn dark purple.
Meningococci and gonococci grow best on media containing heated blood and in an atmosphere containing 5% CO2 (eg, candle jar).
-The organisms are rapidly killed by drying, sunlight, moist heat, and many disinfectants.
Neisseria gonorrhoeae
Gonococci oxidize only glucose and differ antigenically from the other neisseriae.Gonococci usually produce smaller colonies than those of the other neisseriae.
Antigenic Structure
N gonorrhoeae is antigenically heterogeneous and capable of changing its surface structures. Surface structures include:1-Pili (Fimbriae) are the hair-like appendages that enhance attachment to host cells and resistance to phagocytosis.
2-Por protein extends through the gonococcal cell membrane. They may impact intracellular killing of gonococci within neutrophils.
3-Opa Proteins function in adhesion of gonococci within colonies and in attachment of gonococci to host cell receptors.
4-Rmp (Protein III) This protein is antigenically conserved in all gonococci.
5-Lipooligosaccharide Toxicity in gonococcal infections is largely due to the endotoxic effects of LOS.
Genetics & Antigenic Heterogeneity
Gonococci have evolved mechanisms for frequently switching from one antigenic form to another antigenic form which helps the gonococci elude the host immune system.
Gonococci contain several plasmids of unknown function. Two plasmids contain genes that code for penicillinases-lactamases, which causes resistance to penicillin. These plasmids are transmissible by conjugation among gonococci
Virulence factors
CapsulePilli
Cell membrane proteins
LOS
IgA protease
Pathogenesis, Pathology, & Clinical Findings
Gonococci attack mucous membranes of the genitourinary tract, eye, rectum, and throat.In males, there is usually urethritis, with yellow, creamy pus and painful urination. As suppuration subsides in untreated infection, fibrosis occurs, sometimes leading to urethral strictures. Urethral infection in men can be asymptomatic.
In females, the primary infection is in the endocervix and extends to the urethra and vagina, giving rise to mucopurulent discharge. It may then progress to the uterine tubes, causing salpingitis, fibrosis, and obliteration of the tubes. Infertility occurs in 20% of women with gonococcal salpingitis. Chronic gonococcal cervicitis or proctitis is often asymptomatic.
Gonococcal endocarditis is an uncommon but severe infection. Gonococci sometimes cause bacteremia, meningitis and eye infections in adults.
Gonococcal ophthalmia neonatorum, an infection of the eye of the newborn, is acquired during passage through an infected birth canal. The initial conjunctivitis rapidly progresses and, if untreated, results in blindness.
Diagnostic Laboratory Tests
SpecimensSpecimen should be collected using Dacron swab.
Specimen may come from urethra in male and endocervix in female or other sources.
Direct plating is essential (GC susceptible to drying). Transport media may be used (plated within 6 hr).
Direct Microscopic examination:
Direct gram stain for genital specimens. Demonstration of gram negative intracellular diplococci correlates with culture.
Culture :
Enriched culture media used for include modified Thayer Martin (MTM), Martin Lewis (ML)., and New York City (NYC) media. Antibiotic is added to make the media more selective.
The culture is incubated 3-7 % CO2 (candle jar) at moist 35-37C for 24-72hr.
Identification
Colonial morphology: Colonies are raised, small and translucent.
Gram stain.Oxidase test.
CHO utilization test (glucose, maltose, sucrose and lactose).
Nucleic Acid Amplification Tests: for direct detection of N gonorrhoeae in genitourinary specimens.
Serology: antibodies can be detected by immunoblotting, radioimmunoassay, and ELISA (enzyme-linked immunosorbent assay) tests.
Immunity
Repeated gonococcal infections are common. Protective immunity to reinfection does not appear to develop as part of the disease process, because of the antigenic variety of gonococci.Treatment
The uncomplicated genital or rectal infections treated with ceftriaxone (125 mg) given intramuscularly as a single dose. Additional therapy with azithromycin 1 g orally in a single dose or with doxycycline 100 mg orally twice a day for 7 days is recommended for the possible concomitant chlamydial infection.Neisseria meningitidis
Antigenic StructureAt least 13 serogroups of meningococci have been identified by immunologic specificity of capsular polysaccharides. The most important serogroups associated with disease in humans are A, B, C, X, Y, and W-135. Group C and group A are associated with epidemic disease.
As many as 20 serotypes have been defined; serotypes 2 and 15 have been associated with epidemic disease.
Virulence factors
Capsule : N. meningitidis stains are frequently encapsulated and 13 different capsular serogroups are found. The capsule render the mo resistant to phagocytosis and enhance organism survival during bloodstream and CNS invasion.Pili: pili mediate attachment of mo to the epithelia lining of the nasopharngeal epith.
Outer membrane protein: the OMPs of NM are divided into 5 classes. Class1 and class2 are responsible for serotyping specificity.
LOS same as GC.
IgA protease .
Plasmids: are uncommon in NM. However beta lactamases encoding plasmids from GC can be transferred to NM.
Pathogenesis, Pathology, & Clinical Findings
The nasopharynx is the portal of entry. The organisms attach to epithelial cells with the aid of pili; they may form part of the transient flora without producing symptoms. From the nasopharynx, organisms may reach the bloodstream, producing bacteremia; the symptoms may be like those of an upper respiratory tract infection. Fulminant meningococcemia is more severe, with high fever and hemorrhagic rash; there may be disseminated intravascular coagulation and circulatory collapse (Waterhouse-Friderichsen syndrome).
Meningitis is the most common complication of meningococcemia. It usually begins suddenly, with intense headache, vomiting, and stiff neck, and progresses to coma within a few hours.
During meningococcemia, there may be interstitial myocarditis, arthritis, and skin lesions. In meningitis, the meninges are acutely inflamed, with thrombosis of blood vessels and exudation of polymorphonuclear leukocytes, so that the surface of the brain is covered with a thick purulent exudate.
Diagnostic Laboratory Tests
SpecimensSpecimens of blood are taken for culture, and specimens of spinal fluid are taken for smear and culture.
Smears
Gram-stained smears of the sediment of centrifuged spinal fluid often show typical Neisseriae within polymorphonuclear leukocytes or extracellularly.
Culture
Cerebrospinal fluid specimens are plated on "chocolate" agar and incubated at 37°C in an atmosphere of 5% CO2 (candle jar). A modified Thayer-Martin medium with antibiotics favors the growth of neisseriae, inhibits many other bacteria. Presumptive colonies of neisseriae on solid media, particularly in mixed culture, can be identified by Gram's stain and the oxidase test. Spinal fluid and blood generally yield pure cultures that can be further identified by carbohydrate oxidative reactions.
Serology
Antibodies to meningococcal polysaccharides can be measured by latex agglutination or hemagglutination tests.
Immunity
Immunity to meningococcal infection is associated with the presence of specific bactericidal antibodies in the serum. These antibodies develop after subclinical infections with different strains or injection of antigens and are group-specific, type-specific. A tetravalent conjugate vaccine is licensed for use in persons 11–55 years of age. Routine vaccination of young adolescents and the risk groups: persons with functional or surgical asplenia; travelers to highly endemic areas and the military populations; and for clinical laboratory workers (microbiologists).Treatment
Penicillin G is the drug of choice for treating meningococcal disease. Either chloramphenicol or a third-generation cephalosporin such as cefotaxime or ceftriaxone is used in persons allergic to penicillins.Epidemiology, Prevention, & Control
Meningococcal meningitis occurs in epidemic waves (eg, in military encampments) and a smaller number of sporadic interepidemic cases. During epidemics, the carrier rate goes up to 70–80%. Rifampin, 600 mg orally twice daily for 2 days (or ciprofloxacin in adults, 500 mg as a single dose), can often eradicate the carrier state and serve as chemoprophylaxis for household and other close contacts.
Other Neisseriae
Neisseria lactamica very rarely causes disease but is important because it grows in the selective media (eg, modified Thayer-Martin medium) used for cultures of gonococci and meningococci from clinical specimens. N lactamica can be cultured from the nasopharynx of 3–40% of persons and most often is found in children. Unlike the other neisseriae, it ferments lactose.
Moraxella catarrhalis
It is a member of the normal flora in 40–50% of healthy school children. M catarrhalis causes bronchitis, pneumonia, sinusitis, otitis media, and conjunctivitis. It is also of concern as a cause of infection in immunocompromised patients. Most strains of M catarrhalis from clinically significant infections produce β-lactamase. M catarrhalis can be differentiated from the neisseriae by its lack of carbohydrate fermentation and by its production of DNase.• The M.O
• Glucose• Maltose
• Sucrose
• Lactose
• N. gonorrohoea
• +
• -
• -
• -
• N. meningitidis
• +
• +
• -
• -
• N lactamica
• +
• +
• -
• +
• Moraxella
• -
• -
• -
• -